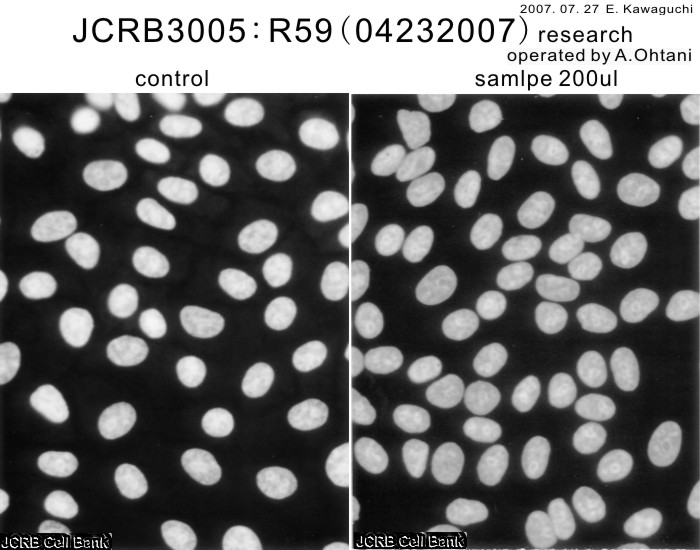

JCRB3005 R59
細胞情報
細胞種類:高発がん性遺伝病患者由来細胞コレクション (細胞分譲手数料はこちら)
| 細胞番号(JCRB) | JCRB3005 | 細胞名 | R59 |
|---|---|---|---|
| 生物種(日本語) | ヒト | 組織名(日本語) | 神経系 |
| コメント(日本語) | 網膜芽腫(両側性)由来 (寄託番号: KURB2344) | プロフィール | Hereditary disease with high cancer risk Retinoblastoma (autosomal dominant) sporadic bilateral tumor |
| 別名 | 動物名 | human | |
| 系統名 | 学名・属名 | Homo | |
| 学名・種小名 | sapiens | 性別 | F |
| 年齢・月齢 | 細胞識別情報 | available | |
| (癌)原発組織名 | tumor | 病歴情報 | Retinoblastoma (sporadic bilateral) |
| 転移の有無(Y/N) | (癌)転移組織名 | ||
| 遺伝的性質 | 細胞寿命 | ||
| クライシスPDL | 形態 | ||
| 一般性状 | tumor | 細胞分類 | tumor |
| 細胞樹立者名 | Dr. Inomata M. (National Cancer Center) | 細胞寄託者 | Radiation Biology Center, Kyoto University |
| 分譲時制限 | コメント | same patient as KURB2342 RB188(rcurrence) | |
| 入手年 | 培養培地 | RPMI1640 containing 20% heat-inactivated fetal calf serum and 20μM β-mercaptoethanol | |
| 継代方法 | 継代時細胞数 | ||
| 人種 | Japanese | 炭酸ガス濃度 | |
| 採取組織名 | 組織型 |
| ウイルスDNA・RNA検出検査 (Detection of virus genome fragment by Real-time PCR) | |||||||||
|---|---|---|---|---|---|---|---|---|---|
| ウイルスDNA 検出検査 |
not tested | ウイルスRNA 検出検査 |
not tested | ||||||
| Images |
|---|
|